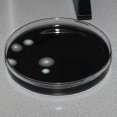

Legionellatest (inclusief type bepaling)
Het risico van een besmetting met een Legionella-bacterie is groot bij waterinstallaties die aerosolen ofwel verneveling produceren zoals dentalunits, losse tandsteenapparatuur en douches. Daarom is het verplicht (Arbowetgeving) jouw dentalunit periodiek te laten controleren op Legionella. Daarnaast dien je (KNMT-richtlijnen) jouw water te controleren op Legionella bij een constatering van 10.000 KVE/ml aan bacteriën na een watertest.
Behandeling Legionella
Dental WaterTest voert Legionellatesten uit inclusief type bepaling, volgens de NEN6265 en NEN6254 norm. Wanneer het resultaat op het rapport >100 KVE/l aangeeft, is er sprake van een overschrijding van de norm. De KNMT-richtlijnen stellen dat vervolgens actie ondernomen moet worden totdat de waterkwaliteit wel voldoet aan de norm. Mocht Legionella pneumophila (serotype 1) worden aangetroffen, dan moet jouw praktijk per direct gesloten worden om alle waterleidingen te reinigen. Dental WaterTest kan helpen bij het weer op orde krijgen en houden van de waterkwaliteit.
Gevaar van Legionella
Legionellapneumonie ofwel de veteranenziekte is één van de aandoeningen die de Legionellabacterie kan veroorzaken. De Legionellabacterie komt via het inademen van kleine waterdruppels (aerosolen) in de longen. Ouderen, kinderen, zieken en mensen met een verzwakt afweersysteem lopen het grootste risico. In Nederland overlijden er nog altijd enkele tientallen mensen per jaar aan deze ziekte. Anderen houden er chronische klachten aan over. Voor mondzorgpraktijken is het daarom van belang om periodiek Legionella monsters te laten nemen en een eventuele besmetting zo snel mogelijk te elimineren.
Controle op legionella
Gemakkelijk, wij nemen alles voor je uit handen
Het proces is VOLLEDIG geaccrediteerd en het personeel opgeleid
Betrouwbaar, wij werken onafhankelijk en vertrouwelijk
Inclusief type bepaling, volgens de NEN6265 en NEN6254 norm
Bij overschrijding norm indien gewenst advies en begeleiding